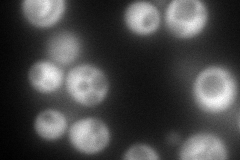
YGR124W
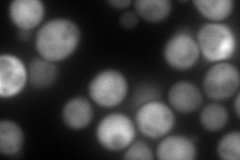
YGR124W
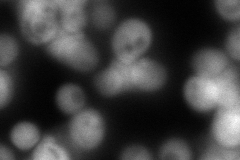
YGR124W
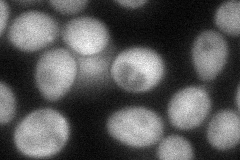
YGR124W
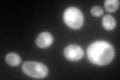
YGR124W

View description
Asparagine synthetase, isozyme of Asn1p; catalyzes the synthesis of L-asparagine from L-aspartate in the asparagine biosynthetic pathway
Localization:
Intensity:
Fold change:
Significance:
-
C’ GFP library in SD

cytosol283.87 -
N' NOP1pr-GFP in SD
cytosol232.457 -
N' TEF2pr-mCherry in SD
cytosol262.293 -
N' NATIVEpr-GFP in SD
cytosol139.029 -
N' TEF2pr-VC and Cyto-VN in SD
cytosol70.9524 -
C’ GFP library in SD+DTT

cytosol393.721.38No -
C’ GFP library in SD+H2O2

cytosol403.251.42No -
C’ GFP library in Starvation Media
cytosol161.80.56No -
C’ GFP library on the background of Pup2-DaMP

cytosol -
C’ GFP library on the background of CCT mutant

cytosol311.4011.09695No
